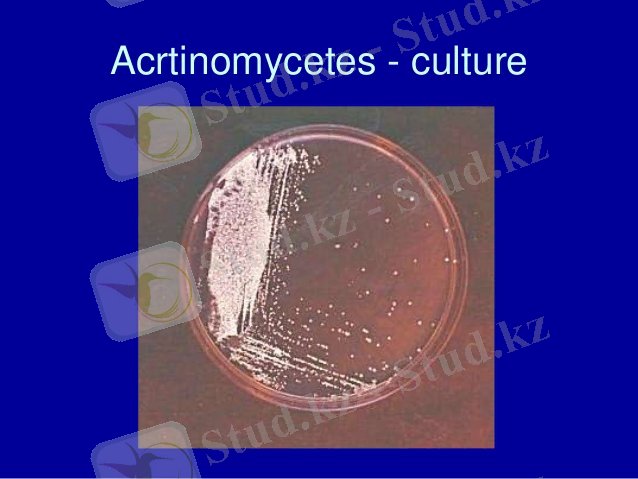

Актиномицеттер және актиномикоз: морфологиясы, классификациясы, патогенезі, лабораториялық диагностикасы және алдын алу мен емдеу


МАРАТ ОСПАНОВ АТЫНДАҒЫ БАТЫС ҚАЗАҚСТАН МЕМЛЕКЕТТІК МЕДИЦИНА УНИВЕРСИТЕТІ

СТУДЕНТТІҢ ӨЗІНДІК ЖҰМЫСЫ
Мамандығы: Жалпы медицина
Кафедра: Микробиология, вирусология және иммунология
Дисциплина: Микробиология және иммунология
Курс: ІІ
Тобы: 212 «Б»
Тақырыбы : «Актиномицеттер. Актиномикоз қоздырғышы. Адам мен жануар үшін патогенділігі. Ағзада шоғырлануы. Иммунитет. Актиномикоздың лабораториялық анықтауы. Алдын алуы мен емдеу»
Орындау түрі: Реферат
Орындаған: Қалман С. \Ғ
Тексерген: Нурсейтова Т. Х
Ақтөбе 2018 ж.
Жоспары:
І. Кіріспе
ІІ. Негізгі бөлім
А) Актиномицеттерге жалпы сипаттамасы, классификациясы және қасиеттері
Б) Актиномицеттерге жалпы сипаттама
В) Актиномицеттердің құрылымы
Г) Актиномицеттердің классификациясы. Streptomyces туысы.
Д) Актиномицеттердің патогенезі
Ж) Актиномицеттерден емдеу
ІІІ. Қорытынды
Кіріспе
Топырақ микроорганизмдері биологиялық белсенділігі және құрамы бойынша алуан түрлі болып келеді. Бұл бактериялар, актиномицеттер, саңырауқұлақтар, балдырлар және қарапайымдылар. Микроорганизмдер салмағы тек үстіңгі беткей горизонтының өзінде ғана бір гектарға бірнеше тоннаны құрайды. Микроорганизмдер саны 1 г топыраққа жүздеген мыңдар мен миллионға дейін жетеді. Жалпы, микроорганизмдер мөлшері жағынан планетамыздың құрлық бөлігінің 0, 01-0, 1%-ын алып жатыр 1. Топырақ фаунасының әрбір мекендеушісі өзінің тіршілігін жалғастыру мақсатында алуан түрлі функциялар атқарады. Ал бұл функциялар өз кезегінде организмдердің ерекше қасиеттеріне негізделеді. Осының ішінде бұл курстық жұмыста топырақ микрофлорасында айрықша орынға және спецификалық қасиетке ие актиномицеттер қарастырылады. Курстық жұмыстың өзектілігі: Актиномицеттер өздерінің антибиотикалық заттарды синтездеуіне байланысты үлкен қызығушылық тудыруда. Сонымен қоса, актиномицеттер жоғарғы және төменгі сатыдағы организмдердің өсуін және дамуын стимулдейтін биологиялық активті заттар түзуге қабілетті. Актиномицетті шығу тегі бар заттар мал шаруашылығында және өсімдік шаруашылығында зиянкестермен күресуде орны ерекше. Барлық актиномицеттер делік B тобына жататын витаминдерді синтездейді. Сондықтан да актиномицеттердің ерекше қасиеттерін анықтау, зерттеу қазірігі таңда өзекті мәселе.
НЕГІЗГІ БӨЛІМ
А) Актиномицеттерге жалпы сипаттама, классификациясы және қасиеттері Актиномицеттер (ескі атауы: сәулелі саңырауқұлақтар) - диаметрі 0, 4-1, 5 мкм-ге дейін жететін даму сатыларының кейбір стадияларында бұтақтанған мицелий құруға қабілеті бар бактериялар (кейбір ғалымдар актиномицеттердің бактериалды табиғатына байланысты саңырауқұлақтық мицелий аналогы - жіңішке жіпшелер деп атайды) тобы. Клетка қабырғасының типі бойынша Гр+ және ДНҚ құрамында ГЦ жұптарының мөлшері - 60-75%. Ең кең таралған жері - топырақ: оның құрамында актиномицеттердің барлық туыс өкілдері кездеседі. Люминесцентті микроскопия көмегімен анықталатын прокариотты биомассаның 10-15% мөлшерін және дәстүрлі қоректік орталарда сұйытылған топырақ суспензиясын егу кезінде өсіп шығатын бактериялардың ¼ бөлігін құрайды

Актиномицеттердің арасында аэробтар және анаэробтар, мезофилдер мен термофилдер бар. Көбінесе актиномицеттер сапрофиттер, алайда араларында адамдарға, жануарларға, өсімдіктерге зиян келтіретін паразитті түрлері кездеседі. Actinomycetes классына қалыпты актиномицеттерден басқа, проактиномицеттер, микобактериялар және микококкалар жатқызылады 3. Проактиномицеттер актиномицеттерден мицелийдің дамудың ерте кезеңінде ған болуымен ерешеленеді. Одан кейін жас жіпшелер коккалар мен таяқшаларға дейін үзіледі. Соңғы жылдары актиномицеттер адам қажеттілігіне сай көптеген алуан түрлі физиологиялық белсенді заттарды продуцирлейтін қабілеттілігіне байланысты практикада кең қолданысқа ие. Актиномицеттердің көптеген дақылдарынан дәрілік препараттар - тағам өнеркәсібінде, өсімдік өнеркәсібінде, ветеринарияда, медицинада қолданылатын антибиотиктер. Актиномицеттер витаминдер, гормондар, ферменттер, токсиндер, өсу заттары, аминоқышқылдар және адам үшін қажетті басқа да биологиялық белсенді заттар түзуге қабілетті. Топырақ құнарлылығын қалыптастыру және топырақ шығару процесстеріне актиномицеттер белсенді түрде қатысады. Оларға топырақты қалпына келтіруді жүзеге асыратын көптеген функцияларды жатқызады. Ең алғаш болып актиномицеттерді 1878 жылы Ц. Гарц анықтаған болатын. 1945 жылы С. Ваксман және А. Шатц актиномицеттер дақылдарынан медицинада кең қолданыс тапқан стрептомицин антибиотигін бөліп алды
В) Актиномицеттердің құрылымы
Жоғары сатыдағы актиномицеттердің мицелийі өте жақсы дамыған. Жіңішке гиф диаметрі - 0, 1-1, 0 мкм, ал айрықша жуан гифтер - 1, 5 мкм-ге дейін жетеді. Тығыз агарланған қоректік орталарда (беттік егу) мицелийдің 3 типін анықтауға болады: субстратты, ауалы, субстрат алды немесе колониялар. Субстратты мицелий ортаның тереңдігінде дамиды және “тамыр жүйесі” қызметін атқарады. Оның жіпшелері қоректік заттарды өздеріне сіңіреді де колонияларға тасымалдайды, ал ол жерден ауалы мицелийге ауысады. Субстрат алды мицелийі агарланған ортаның бетінде дамиды және көлемі жағына үлкен жіне кіші колониялардың таралуы жүреді. Актиномицеттердің колониялары тығыз, көн тәрізді және ортамен тұтасып өседі. Ұсақ колониялар мөлшері -0, 5-2 мм, ал ірі колониялар 1 см-ге дейін жетеді 3, 4. Колониялардың сыртқы көрінісі де алуан түрлі: тегіс, бұдыр, қатпарлы, түйіршікті. Актиномицеттердің ауалы мицелийі колонияның беткі қабатында қалыптасады. Актиномицеттердің клеткалары негізгі бірнеше бөліктерден құралған. Клетка қабықшамен - 0, 01-0, 03 мкм көлемі бар қабырғасы болады 3. Мицелий қабықшаларының бетінде шырышты капсула орналасқан, көбіне ол өте жұқа және тығыз емес жүйе болып келеді.

Г) Актиномицеттердің классификациясы
Актиномицеттердің систематикасы үшін микроорганизмдердің бұл тобына жататын микробтарға тән қасиеттер анықталды. Сонымен қатар, зерттеу барысында актиномицеттер түрлерінің морфологиялық өзгергіштіктері, ұрпақ беру органдарының құрылымы және даму дәрежесі, споратасушылар сипаты, спора қабықшасының құрылымы сияқты көрсеткіштер есепке алынды. Жалпы, Actinomycetes класы 2 қатардан құрылған. Actinoplanales - қозғалмалы және Actinomycetales - қозғалмайтын. Класс 26 туысы бар 6 тұқымдасты біріктіреді Тұқымдастары: ACTINOMYCETACEAE, MICROMONOSPORACEAE, STREPTOSPORANGIACEAE, ACTINOPLANACEAE, DERMATOPHILACEAE, PLANOSPORACEAE. Streptomyces туысы - Actinomycetales қатары Streptomycetaceae тұқымдасына жататын топырақ актиномицеттерінің туысы, тұқымдастың ең үлкен туысы (500-ден астам түрі бар) . Көптеген антибиотиктердің продуценттері ретінде танымал.
Ж) Актиномицеттердің патогенезі
Жануарлардағы патогенезі . Патогенді актиномицеттер ірі қара малдарды ауруға шалдықтырады. Кейде шошқа, жылқыларды зақымдауы мүмкін. Зақымдалу созылмалы түрде өтеді. Көбінесе тері, тіл, ерін, бет, мойын, кейде сүйек зақымдалады.
Адамдардағы актиномицеттердің патогенезі. Инкубациялық кезең 2-3 аптадан-бірнеше жылға дейін. Инфекция көзі - ірі қара мал, жылқы, шошқа, ит, қоян, жабайы жануарлар және кейбір қоршаған орта объектілері (топырақ, өсімдік, ауа, дәнді дақылдар) болады. Түсу ошағы өкше болса, өкше мицетомасы дамиды.
Актиномикоз асқорыту жүйесі арқылы қоздырғыштың эндогенді түсуі нәтижесінде дамиды. Дәнді дақылдарды шайнау және терінің, шырышты қабықтың зақымдалуы, әсіресе кариесті тістің болуы - аурудың ілгері дамуына әкеледі. Енген қоздырғыш дәнекер тін арқылы, қан және лимфалық жол арқылы таралады.
Инфекциялық процесс инфильтраттың, іріңді аймақтардың пайда болуымен көрінеді. Ауру созылмалы қабыну, кейіннен іріңді үрдіске әкелетіндігімен сипатталады. Локализация ошағында тығыз инфильтраттар пайда болады. Тері көкшіл болады. Инфильтраттардан ұнамсыз иісті ірің шығады. Іріңде актиномицет жасушаларынан тұратын дәндер анықталады.
Клиникалық көрінісі бойынша бет-мойын актиномикозын, өкпе, ішкі ағзалар, тері, бұлшықеттік, мұрын, құлақ, көмей, өңеш, ОЖЖ-нің актиномикозын ажыратады.
Ж) Актиномицеттерден емдеу
Актинолизаттар, актиномицетті көпвалентті вакцинасы, антибиотиктер және сульфаниламидті препараттар, йод препараттарын тағайындайды. Кейде рентгенотерапия мен хирургиялық жолды қоланады.
Алдын алу. Жеке гигиенаны сақтау, әсіресе тері мен шырышты қабықтарды зақымданудан қорғау, тісті күту, қолды жуу.
... жалғасы- Іс жүргізу
- Автоматтандыру, Техника
- Алғашқы әскери дайындық
- Астрономия
- Ауыл шаруашылығы
- Банк ісі
- Бизнесті бағалау
- Биология
- Бухгалтерлік іс
- Валеология
- Ветеринария
- География
- Геология, Геофизика, Геодезия
- Дін
- Ет, сүт, шарап өнімдері
- Жалпы тарих
- Жер кадастрі, Жылжымайтын мүлік
- Журналистика
- Информатика
- Кеден ісі
- Маркетинг
- Математика, Геометрия
- Медицина
- Мемлекеттік басқару
- Менеджмент
- Мұнай, Газ
- Мұрағат ісі
- Мәдениеттану
- ОБЖ (Основы безопасности жизнедеятельности)
- Педагогика
- Полиграфия
- Психология
- Салық
- Саясаттану
- Сақтандыру
- Сертификаттау, стандарттау
- Социология, Демография
- Спорт
- Статистика
- Тілтану, Филология
- Тарихи тұлғалар
- Тау-кен ісі
- Транспорт
- Туризм
- Физика
- Философия
- Халықаралық қатынастар
- Химия
- Экология, Қоршаған ортаны қорғау
- Экономика
- Экономикалық география
- Электротехника
- Қазақстан тарихы
- Қаржы
- Құрылыс
- Құқық, Криминалистика
- Әдебиет
- Өнер, музыка
- Өнеркәсіп, Өндіріс
Қазақ тілінде жазылған рефераттар, курстық жұмыстар, дипломдық жұмыстар бойынша біздің қор #1 болып табылады.



Ақпарат
Қосымша
Email: info@stud.kz